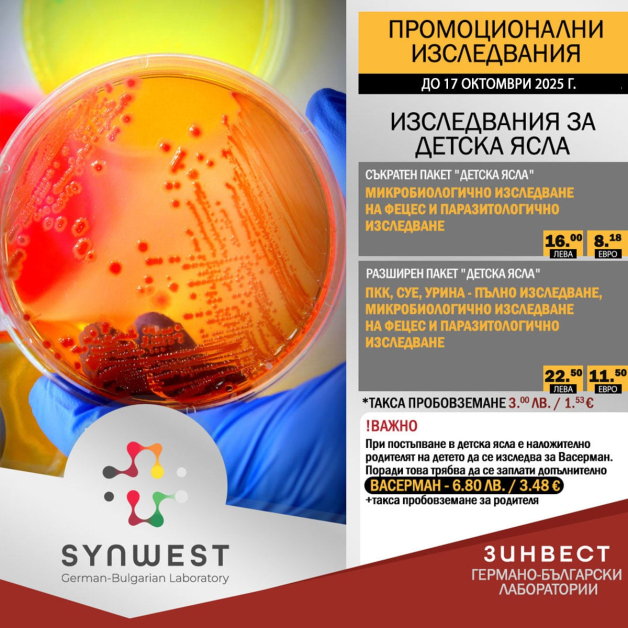
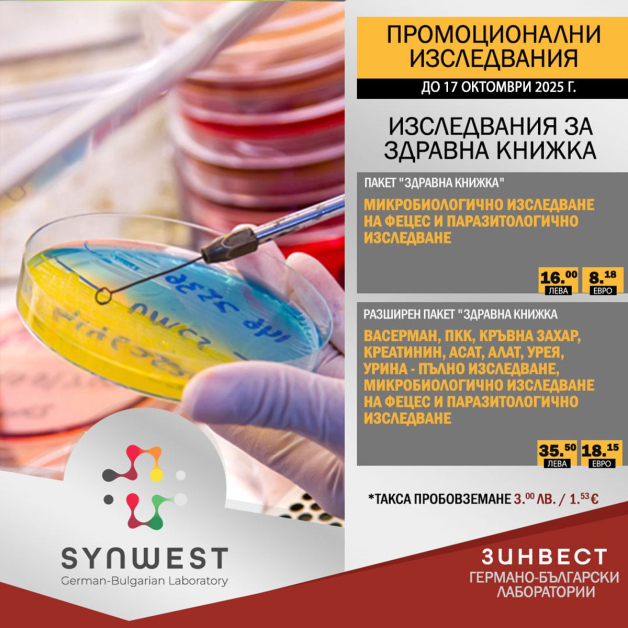
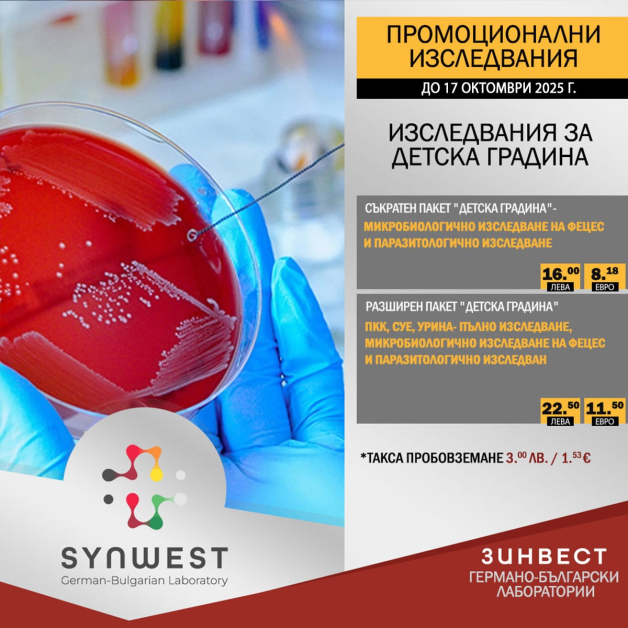

–Я–∞–Ї–µ—В–љ–Є –Є–Ј—Б–ї–µ–і–≤–∞–љ–Є—П –Ј–∞ –Ј–і—А–∞–≤–љ–∞ –Ї–љ–Є–ґ–Ї–∞ –Є —Й–Є—В–Њ–≤–Є–і–љ–∞ –ґ–ї–µ–Ј–∞ –љ–∞ —Б–њ–µ—Ж–Є–∞–ї–љ–Є —Ж–µ–љ–Є
–У–µ—А–Љ–∞–љ–Њ-–±—К–ї–≥–∞—А—Б–Ї–∞ –ї–∞–±–Њ—А–∞—В–Њ—А–Є—П „–Ч–Є–љ–≤–µ—Б—В“ (SYNWEST) —Г–і—К–ї–ґ–∞–≤–∞ –і–Њ 19 –Њ–Ї—В–Њ–Љ–≤—А–Є –Ї–∞–Љ–њ–∞–љ–Є—П—В–∞ —Б–Є —Б –Є–Ј—Б–ї–µ–і–≤–∞–љ–Є—П –љ–∞ –њ—А–Њ–Љ–Њ—Ж–Є–Њ–љ–∞–ї–љ–Є —Ж–µ–љ–Є, –љ–∞—Б–Њ—З–µ–љ–Є –Ї—К–Љ —А–Њ–і–Є—В–µ–ї–Є, –і–µ—Ж–∞ –Є —А–∞–±–Њ—В–µ—Й–Є, –≤–Ї–ї—О—З–Є—В–µ–ї–љ–Њ –Ј–∞ –і–µ—В—Б–Ї–Є –Ј–∞–≤–µ–і–µ–љ–Є—П –Є –Ј–і—А–∞–≤–љ–∞ –Ї–љ–Є–ґ–Ї–∞. –Ю—Б–≤–µ–љ —Б—В–∞–љ–і–∞—А—В–љ–Є—В–µ —В–µ—Б—В–Њ–≤–µ, –ї–∞–±–Њ—А–∞—В–Њ—А–Є—П—В–∞ –њ—А–µ–і–ї–∞–≥–∞ –Є —Б–њ–µ—Ж–Є–∞–ї–љ–Є —Ж–µ–љ–Є –Ј–∞ –Є–Ј—Б–ї–µ–і–≤–∞–љ–Є—П –љ–∞ —Е–Њ—А–Љ–Њ–љ–Є, –Њ—В—А–∞–Ј—П–≤–∞—Й–Є —Д—Г–љ–Ї—Ж–Є—П—В–∞ –љ–∞ —Й–Є—В–Њ–≤–Є–і–љ–∞—В–∞ –ґ–ї–µ–Ј–∞, –Ї–∞–Ї—В–Њ –Є –Ј–∞ –Ї–∞–ї–њ—А–Њ—В–µ–Ї—В–Є–љ –≤—К–≤ —Д–µ—Ж–µ—Б – –Љ–∞—А–Ї–µ—А –Ј–∞ –≤—К–Ј–њ–∞–ї–µ–љ–Є—П –љ–∞ —З–µ—А–≤–∞—В–∞. –І–∞—Б—В –Њ—В –Ї–∞–Љ–њ–∞–љ–Є–є–љ–Є—П –њ–∞–Ї–µ—В –≤–Ї–ї—О—З–≤–∞ –Є –±–µ–Ј–њ–ї–∞—В–љ–Є –Є–Ј—Б–ї–µ–і–≤–∞–љ–Є—П –љ–∞ —З–µ—А–љ–Њ–і—А–Њ–±–љ–Є –µ–љ–Ј–Є–Љ–Є –Р–Ы–Р–Ґ –Є –Р–°–Р–Ґ.
–Ъ–∞–Ї–≤–Њ –≤–Ї–ї—О—З–≤–∞ –Ї–∞–Љ–њ–∞–љ–Є—П—В–∞ –Ј–∞ —Б–µ–њ—В–µ–Љ–≤—А–Є 2025 –≥.?
–Ф–µ—В—Б–Ї–Є –њ–∞–Ї–µ—В–Є:
· –°—К–Ї—А–∞—В–µ–љ –њ–∞–Ї–µ—В „–Ф–µ—В—Б–Ї–∞ –≥—А–∞–і–Є–љ–∞“ – –Љ–Є–Ї—А–Њ–±–Є–Њ–ї–Њ–≥–Є—З–љ–Њ –Є –њ–∞—А–∞–Ј–Є—В–Њ–ї–Њ–≥–Є—З–љ–Њ –Є–Ј—Б–ї–µ–і–≤–∞–љ–µ –љ–∞ —Д–µ—Ж–µ—Б: 16.00 –ї–≤. / 8.18 €
· –†–∞–Ј—И–Є—А–µ–љ –њ–∞–Ї–µ—В „–Ф–µ—В—Б–Ї–∞ –≥—А–∞–і–Є–љ–∞“ – –Я–Ъ–Ъ, –°–£–Х, —Г—А–Є–љ–∞, –Љ–Є–Ї—А–Њ–±–Є–Њ–ї–Њ–≥–Є—П –Є –њ–∞—А–∞–Ј–Є—В–Њ–ї–Њ–≥–Є—П: 22.50 –ї–≤. / 11.51 €
· –°—К–Ї—А–∞—В–µ–љ –њ–∞–Ї–µ—В „–Ф–µ—В—Б–Ї–∞ —П—Б–ї–∞“ – –Љ–Є–Ї—А–Њ–±–Є–Њ–ї–Њ–≥–Є—П –Є –њ–∞—А–∞–Ј–Є—В–Њ–ї–Њ–≥–Є—П: 16.00 –ї–≤. / 8.18 €
· –†–∞–Ј—И–Є—А–µ–љ –њ–∞–Ї–µ—В „–Ф–µ—В—Б–Ї–∞ —П—Б–ї–∞“ – –Я–Ъ–Ъ, –°–£–Х, —Г—А–Є–љ–∞, –Љ–Є–Ї—А–Њ–±–Є–Њ–ї–Њ–≥–Є—П –Є –њ–∞—А–∞–Ј–Є—В–Њ–ї–Њ–≥–Є—П: 22.50 –ї–≤. / 11.51 €
· –Т–∞—Б–µ—А–Љ–∞–љ –Ј–∞ —А–Њ–і–Є—В–µ–ї: 6.80 –ї–≤. / 3.48 € + —В–∞–Ї—Б–∞ –њ—А–Њ–±–Њ–≤–Ј–µ–Љ–∞–љ–µ 3.00 –ї–≤. / 1.53 €
–Ш–Ј—Б–ї–µ–і–≤–∞–љ–Є—П –Ј–∞ –Ј–і—А–∞–≤–љ–∞ –Ї–љ–Є–ґ–Ї–∞:
· –С–∞–Ј–Њ–≤ –њ–∞–Ї–µ—В – –Љ–Є–Ї—А–Њ–±–Є–Њ–ї–Њ–≥–Є—П –Є –њ–∞—А–∞–Ј–Є—В–Њ–ї–Њ–≥–Є—П: 16.00 –ї–≤. / 8.18 €
· –†–∞–Ј—И–Є—А–µ–љ –њ–∞–Ї–µ—В – –њ—К–ї–µ–љ –њ–∞–љ–µ–ї —Б –Т–∞—Б–µ—А–Љ–∞–љ, –Я–Ъ–Ъ, –Ъ—А—К–≤–љ–∞ –Ј–∞—Е–∞—А, –Р–°–Р–Ґ, –Р–Ы–Р–Ґ, —Г—А–µ—П, –£—А–Є–љ–∞ - –њ—К–ї–љ–Њ –Љ–Є–Ї—А–Њ–±–Є–Њ–ї–Њ–≥–Є—З–љ–Њ –Є–Ј—Б–ї–µ–і–≤–∞–љ–µ –љ–∞ —Д–µ—Ж–µ—Б –Є –њ–∞—А–∞–Ј–Є—В–Њ–ї–Њ–≥–Є—З–љ–Њ –Є–Ј—Б–ї–µ–і–≤–∞–љ–µ, –Ї—А–µ–∞—В–Є–љ–Є–љ –Є –і—А.: 35.50 –ї–≤. / 18.16 €
–Ш–Ј—Б–ї–µ–і–≤–∞–љ–µ –љ–∞ –Ї–Њ–ї–Є—З–µ—Б—В–≤–µ–љ –Ї–∞–ї–њ—А–Њ—В–µ–Ї—В–Є–љ –≤—К–≤ —Д–µ—Ж–µ—Б:
29.00 –ї–≤. / 14.84 €
–Ъ–∞–ї–њ—А–Њ—В–µ–Ї—В–Є–љ—К—В –µ —З—Г–≤—Б—В–≤–Є—В–µ–ї–µ–љ –њ–Њ–Ї–∞–Ј–∞—В–µ–ї –Ј–∞ –≤—К–Ј–њ–∞–ї–Є—В–µ–ї–љ–Є –њ—А–Њ—Ж–µ—Б–Є –≤ —З—А–µ–≤–љ–Є—П —В—А–∞–Ї—В. –Я–Њ–≤–Є—И–µ–љ–Є—В–µ —Б—В–Њ–є–љ–Њ—Б—В–Є –Љ–Њ–≥–∞—В –і–∞ –±—К–і–∞—В —Б–≤—К—А–Ј–∞–љ–Є –љ–µ —Б–∞–Љ–Њ —Б –≤—К–Ј–њ–∞–ї–µ–љ–Є—П, –љ–Њ –Є —Б –њ–Њ–ї–Є–њ–Є –Є–ї–Є –і–Њ—А–Є –Ї–Њ–ї–Њ—А–µ–Ї—В–∞–ї–µ–љ –Ї–∞—А—Ж–Є–љ–Њ–Љ. –Я—А–Є –њ–Њ–≤–Є—И–µ–љ–Є —Б—В–Њ–є–љ–Њ—Б—В–Є —Б–µ –њ—А–µ–њ–Њ—А—К—З–≤–∞ –њ—А–Њ–≤–µ–ґ–і–∞–љ–µ –љ–∞ –Ї–Њ–ї–Њ–љ–Њ—Б–Ї–Њ–њ–Є—П.
–С–µ–Ј–њ–ї–∞—В–љ–Є –Є–Ј—Б–ї–µ–і–≤–∞–љ–Є—П:
· –Р–Ы–Р–Ґ –Є –Р–°–Р–Ґ (–њ–Њ–Ї–∞–Ј–∞—В–µ–ї–Є –Ј–∞ —З–µ—А–љ–Њ–і—А–Њ–±–љ–∞ —Д—Г–љ–Ї—Ж–Є—П): 0.00 –ї–≤. / 0.00 €*
–І–µ—А–љ–Њ–і—А–Њ–±–љ–∞ —Д—Г–љ–Ї—Ж–Є—П:
· –С–∞–Ј–Њ–≤ –њ–∞–Ї–µ—В: 5.50 –ї–≤. / 2.81 €
· –°—В–∞–љ–і–∞—А—В–µ–љ –њ–∞–Ї–µ—В: 18.00 –ї–≤. / 9.20 €
· –†–∞–Ј—И–Є—А–µ–љ –њ–∞–Ї–µ—В: 39.00 –ї–≤. / 19.93 €
–Ш–Ј—Б–ї–µ–і–≤–∞–љ–Є—П –љ–∞ —Й–Є—В–Њ–≤–Є–і–љ–∞ –ґ–ї–µ–Ј–∞:
· TSH: 7.50 –ї–≤. / 3.83 €
· –С–∞–Ј–Њ–≤ –њ–∞–Ї–µ—В (TSH + FT4 + FT3): 22.00 –ї–≤. / 11.24 €
· –†–∞–Ј—И–Є—А–µ–љ –њ–∞–Ї–µ—В (TSH + FT4 + FT3 + –Р–љ—В–Є-TG, –Р–љ—В–Є-TPO, –Ґ–Є—А–µ–Њ–≥–ї–Њ–±—Г–ї–Є–љ): 64.00 –ї–≤. / 32.70 €
*–Т—Б–Є—З–Ї–Є –Є–Ј—Б–ї–µ–і–≤–∞–љ–Є—П –Њ—В –Ї–∞–Љ–њ–∞–љ–Є—П—В–∞, –≤–Ї–ї—О—З–Є—В–µ–ї–љ–Њ –Є –±–µ–Ј–њ–ї–∞—В–љ–Є—В–µ, –љ–µ —Б–∞ –Њ—Б–≤–Њ–±–Њ–і–µ–љ–Є –Њ—В —В–∞–Ї—Б–∞ –њ—А–Њ–±–Њ–≤–Ј–µ–Љ–∞–љ–µ, –Ї–Њ—П—В–Њ –µ 3.00 –ї–≤. / 1.53 € –љ–∞ –њ–∞—Ж–Є–µ–љ—В.
„–Ч–Є–љ–≤–µ—Б—В“ – –ї–∞–±–Њ—А–∞—В–Њ—А–Є—П —Б –µ–≤—А–Њ–њ–µ–є—Б–Ї–Њ –Ї–∞—З–µ—Б—В–≤–Њ
„Synwest“ –µ –≤–µ—З–µ –љ–∞–і 20 –≥–Њ–і–Є–љ–Є –њ–∞—А—В–љ—М–Њ—А—Б–Ї–∞ –ї–∞–±–Њ—А–∞—В–Њ—А–Є—П –Ј–∞ –С—К–ї–≥–∞—А–Є—П –љ–∞ –µ–і–љ–∞ –Њ—В –љ–∞–є-–≥–Њ–ї–µ–Љ–Є—В–µ –µ–≤—А–Њ–њ–µ–є—Б–Ї–Є –ї–∞–±–Њ—А–∞—В–Њ—А–љ–Є –≤–µ—А–Є–≥–Є- Synlab –У–µ—А–Љ–∞–љ–Є—П, –Ї—К–і–µ—В–Њ —Б–µ –Є–Ј–њ—А–∞—Й–∞—В –љ–∞–є-—Б–њ–µ—Ж–Є–∞–ї–Є–Ј–Є—А–∞–љ–Є—В–µ –Є–Ј—Б–ї–µ–і–≤–∞–љ–Є—П – –≤–Ї–ї—О—З–Є—В–µ–ї–љ–Њ –Ј–∞ –Р–ї—Ж—Е–∞–є–Љ–µ—А, –Љ–љ–Њ–ґ–µ—Б—В–≤–µ–љ–∞ —Б–Ї–ї–µ—А–Њ–Ј–∞, —Е—А–∞–љ–Є—В–µ–ї–љ–∞ –љ–µ–њ–Њ–љ–Њ—Б–Є–Љ–Њ—Б—В —Б –њ–µ—А—Б–Њ–љ–∞–ї–Є–Ј–Є—А–∞–љ–∞ 8-–і–љ–µ–≤–љ–∞ —Ж–Є–Ї–ї–Є—З–љ–∞ –і–Є–µ—В–∞ –Є –Є–љ–і–Є–≤–Є–і—Г–∞–ї–љ–Є —А–µ—Ж–µ–њ—В–Є, —З—А–µ–≤–µ–љ –Љ–Є–Ї—А–Њ–±–Є–Њ–Љ —Б –Є–љ–і–Є–≤–Є–і—Г–ї–љ–Є –њ—А–µ–њ–Њ—А—К–Ї–Є –Ј–∞ –Є–Ј–±–Њ—А –љ–∞ –њ—А–Њ–±–Є–Њ—В–Є–Ї ,–ї–µ–Ї–∞—А—Б—В–≤–µ–љ–Њ –Љ–Њ–љ–Є—В–Њ—А–Є—А–∞–љ–µ,–≥–µ–љ–µ—В–Є—З–љ–Є –Є–Ј—Б–ї–µ–і–≤–∞–љ–Є—П –Є –і—А.
–Ш–Ј—Б–ї–µ–і–≤–∞–љ–Є—П –Є –њ—А–Њ—Д–Є–ї–∞–Ї—В–Є–Ї–Є –Ј–∞ —Д–Є—А–Љ–Є –Є –Ї–Њ–ї–µ–Ї—В–Є–≤–Є
–Ы–∞–±–Њ—А–∞—В–Њ—А–Є—П—В–∞ –Є–Ј–≤—К—А—И–≤–∞ –њ—А–Њ—Д–Є–ї–∞–Ї—В–Є—З–љ–Є –Ї–∞–Љ–њ–∞–љ–Є–Є –і–Є—А–µ–Ї—В–љ–Њ –≤—К–≤ —Д–Є—А–Љ–Є –Є –њ—А–µ–і–њ—А–Є—П—В–Є—П —З—А–µ–Ј –Љ–Њ–±–Є–ї–љ–Є —А–∞–±–Њ—В–љ–Є —Б—В–∞–љ—Ж–Є–Є –Ј–∞ –њ—А–Њ–±–Њ–≤–Ј–µ–Љ–∞–љ–µ –Є —А–µ–≥–Є—Б—В—А–∞—Ж–Є—П. –Ц–µ–ї–∞—В–µ–ї–љ–Њ –µ –њ—А–µ–і–≤–∞—А–Є—В–µ–ї–љ–Њ –Ј–∞–њ–Є—Б–≤–∞–љ–µ –љ—П–Ї–Њ–ї–Ї–Њ —Б–µ–і–Љ–Є—Ж–Є –њ–Њ-—А–∞–љ–Њ. –Я—А–µ–і–ї–∞–≥–∞—В —Б–µ –Є —А–µ–і–Ї–Є –Є–Ј—Б–ї–µ–і–≤–∞–љ–Є—П, –љ–∞–њ—А–Є–Љ–µ—А –Ј–∞ —В–µ–ґ–Ї–Є –Љ–µ—В–∞–ї–Є –њ—А–Є —Б–ї—Г–ґ–Є—В–µ–ї–Є –≤ –Є–љ–і—Г—Б—В—А–Є–∞–ї–љ–Є –Њ–±–µ–Ї—В–Є, –Ї–∞—В–Њ —В–µ —Б–µ –∞–љ–∞–ї–Є–Ј–Є—А–∞—В –≤ Synlab –У–µ—А–Љ–∞–љ–Є—П.
–Ы–Њ–Ї–∞—Ж–Є–Є –љ–∞ SYNWEST:
–°–Њ—Д–Є—П, –Я–ї–Њ–≤–і–Є–≤, –°—В–∞—А–∞ –Ч–∞–≥–Њ—А–∞, –•–∞—Б–Ї–Њ–≤–Њ, –Я–∞–Ј–∞—А–і–ґ–Є–Ї, –Р—Б–µ–љ–Њ–≤–≥—А–∞–і, –Ф–Є–Љ–Є—В—А–Њ–≤–≥—А–∞–і, –Я–µ—Й–µ—А–∞, –Ґ–Њ–њ–Њ–ї–Њ–≤–≥—А–∞–і, –Т—А–∞—Ж–∞
–Ч–∞ —Д–Є—А–Љ–µ–љ–Є –Ј–∞–њ–Є—В–≤–∞–љ–Є—П: [email protected]
–°–∞–є—В: synwest.bg
–Ґ–µ–ї–µ—Д–Њ–љ–Є –љ–∞ –Ї–Њ–ї—Ж–µ–љ—В—К—А–∞ : +359 89 999 6921 –Є–ї–Є 0700 800 89